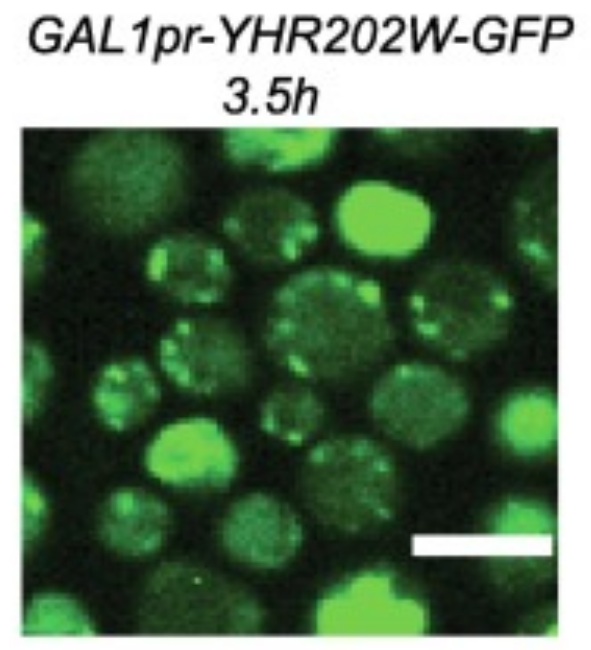
Paper 5

About Me
Life is chemistry — but how does chemistry become life? This question sits at the heart of my research.
I am a protobiologist and biochemist working at the intersection of systems chemistry and molecular evolution,
combining experimental and computational approaches to understand how complex,
self-reproducing systems emerge from simple chemical building blocks.
I obtained my BSc in Biology from Ben-Gurion University, and my MSc in Molecular Biology from the Weizmann
Institute of Science. I conducted research in bacterial ecology, immunology, protein evolution and genomics before
focusing on the origin of life — studying lipid-based self-reproducing catalytic networks in
the lab of Prof. Doron Lancet.
During my PhD in Chemistry at the University of Glasgow, under Prof. Lee Cronin, I further investigated
selection and evolution in chemical systems with Assembly Theory, developing analytical tools to uncover
causation at the molecular scale. I am now a postdoctoral researcher in the lab of Prof. Wilhelm Huck at Radboud
University, where I use AI-driven algorithms and automated platforms to navigate and control combinatorial chemical systems.
My broader scientific goals are to map the informational and functional landscape of living systems, uncover the
fundamentals of selection and evolution, and generate new living systems in the lab.
Outside of science, I spend my time cooking vegan food, sports climbing, hiking, and looking for the next adventure.

Research
-
2026 - present
Active Learning in Combinatorial Chemistry
Researcher in the lab of Prof. Wilhelm Huck.
Formulating AI-driven algorithms to empirically guide and control messy formose-based systems to uncover specific products and system dynamics, using automated experimental platforms and analytics. -
PhD in Chemistry | University of Glasgow
-
2022 - 2025
Selection in Complex Chemical Systems
Researcher in the lab of Prof. Lee Cronin.
Investigated Assembly Theory as a fundamental framework for the study of selection and evolution, through experimentation with advanced analytics and automated systems supported by theoretical work. -
MSc in Molecular Biology | Weizmann Institute of Science
-
2018-2022
Micellar Origin of Life
Researcher in the lab of Prof. Doron Lancet.
Researched the origin of life in a Lipid World scenario using advanced computational modelling and kinetic simulations of self-reproducing complex catalytic networks. -
2020-2020
Functional Genomics
Research Intern in the lab of Prof. Maya Schuldiner.
Predicted the functionality of unexplored enzymes using advanced structural homology, and performed experimental validation. -
2019-2020
Protein Evolution
Research Intern in the lab of Prof. Dan Tawfik.
Examined the functional properties and folding capacities of a primordial RNA-binding protein candidate in the presence of polyamines. -
BSc in Biology | Ben-Gurion University
Ashalim Natural Sciences Honors Program
-
2017-2019
Avian Immunology
Research Assistant in the lab of Prof. Tomer Hertz.
Profiled the antibody repertoires of avian species and identified exposures to influenza and other viruses in relation to migration patterns of wild flocks. -
2018-2019
Microbial Ecology
Research Intern in the lab of Prof. Itzik Mizrahi.
Explored the dynamics of Horizontal Gene Transfer in microbial communities of ruminants.
Publications
Notable Projects:
2024
A Kahana, A MacLeod, H Mehr, A Sharma, E Carrick, M Jirasek, S Walker and L Cronin
arXiv2023
A Kahana, L Segev and D Lancet
CellRepPhysSci2021
A Kahana and D Lancet
NatRevChemOther Selected Projects:
In Preparation
A Kahana, M Jirasek and L Cronin
2026
A Kahana
Life2022
A Kahana, D Lancet and Z Palmai
Life2022
A Kahana*, N Cohen* and M Schuldiner
JMB2022
S Levy, M Abd Alhadi, A Azulay, A Kahana, N Bujanover, R Gazit, M A McGargill, L M Friedman and T Hertz
ICB2020
D Despotović, L M Longo, E Aharon, A Kahana, T Scherf, I Gruic-Sovulj and D S Tawfik
Biochemistry2019
A Kahana, P Schmitt-Kopplin and D Lancet
AstrobiologyFor a full list, see my Google Scholar profile.
Recognition
In addition, I have reviewed scientific papers for Artificial Life (ALIFE), Life (also guest editor), Science Advances, Angewandte Chemie and Discover Life (OLEB)
Associations
Contact